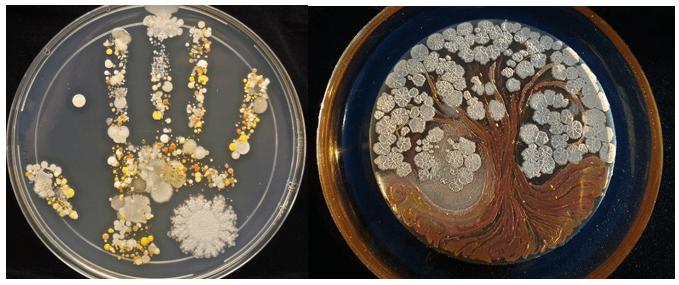
Thực hành tạo dấu vân tay vi khuẩn

Cơ thể vi khuẩn gồm:
- Thành tế bào
- Màng tế bào
- Chất tế bào
- Vùng nhân
- Lông
- Roi
Vi khuẩn là sinh vật có cấu tạo cơ thể đơn giản nhất trong thế giới sống vì cấu tạo cơ thể chúng gần như cấu tạo của một tế bào.
Giải Khoa học tự nhiên lớp 6 bài 27: Vi khuẩn trang 92, 93, 94, 95 hướng dẫn trả lời các câu hỏi trong SGK Khoa học tự nhiên 6 sách Kết nối tri thức. Toàn bộ lời giải bám sát chương trình học để các em học sinh củng cố các bài học trong sách KHTN lớp 6 Kết nối tri thức với cuộc sống. Sau đây mời các bạn tham khảo chi tiết.
Quan sát hình 27.1, nhận xét về hình dạng của các loài vi khuẩn và xếp chúng vào các nhóm khác nhau.

Hướng dẫn trả lời câu hỏi
Các loài vi khuẩn rất đa dạng về hình dạng:
Quan sát hình 27.2, trình bày cấu tạo của tế bào vi khuẩn. Vì sao nói vi khuẩn là sinh vật có cấu tạo cơ thể đơn giản nhất trong thế giới sống?

Cơ thể vi khuẩn gồm:
Vi khuẩn là sinh vật có cấu tạo cơ thể đơn giản nhất trong thế giới sống vì cấu tạo cơ thể chúng gần như cấu tạo của một tế bào.
Quan sát hình 27.3, nêu vai trò của vi khuẩn trong tự nhiên.

Vai trò của vi khuẩn trong tự nhiên:
Em hãy nêu một số ứng dụng của vi khuẩn trong đời sống con người.
Hướng dẫn trả lời câu hỏi
Một vài ứng dụng của vi khuẩn trong thực tiễn:
Tại sao ăn sữa chua hàng ngày có thể giúp con người ăn cơm ngon miệng hơn?
Hướng dẫn trả lời câu hỏi
Ăn sữa chua hàng ngày có thể giúp chúng ta ăn cơm ngon miệng hơn vì trong sữa chua có rất nhiều vi khuẩn có lợi (Lactobacillus Acidophilus và Bifido Bacterium), bảo vệ hệ tiêu hóa, tăng cường sức đề kháng. Do đó giúp chúng ta ăn cơm ngon miệng hơn.
Dựa vào các thông tin trên, em hãy nêu một số biện pháp để phòng bệnh do vi khuẩn gây ra ở người.
Hướng dẫn trả lời câu hỏi
Một số biện pháp để phòng bệnh do vi khuẩn gây ra:
1. Chúng ta có nên sử dụng thức ăn bị ôi thiu hay không? Tại sao?
2. Em hãy nên các biện pháp bảo quản thức ăn tránh bị vi khuẩn làm hỏng.
Hướng dẫn trả lời câu hỏi
1. Không nên sử dụng thức ăn bị ôi thiu. Vì thức ăn bị ôi thiu là do thức ăn không được bảo quản tốt, bảo quản thức ăn không đúng cách dẫn đến các vi khuẩn hoại sinh sinh sôi, mùi vị thay đổi là đã có dấu hiệu nhiễm khuẩn. Nếu ăn vào sẽ đưa trực tiếp các vi khuẩn vào cơ thể, gây hại đến sức khỏe.
2. Một số biện pháp bảo quản:
Thực hành tạo dấu vân tay vi khuẩn
Hướng dẫn trả lời câu hỏi
>> Bài tiếp theo: Khoa học tự nhiên lớp 6 Bài 28: Thực hành Làm sữa chua và quan sát vi khuẩn
---------------------------------
Ngoài lời giải chi tiết KHTN 6 bài 27 Vi khuẩn sách Kết nối tri thức với cuộc sống trên đây, mời các bạn tham khảo Trắc nghiệm Khoa học tự nhiên 6 KNTT và các đề thi học kì 1 lớp 6 trên VnDoc.
Theo Nghị định 147/2024/ND-CP, bạn cần xác thực tài khoản trước khi sử dụng tính năng này. Chúng tôi sẽ gửi mã xác thực qua SMS hoặc Zalo tới số điện thoại mà bạn nhập dưới đây:
Lớp 6
KHTN 6
KHTN 6 Kết nối tri thức
Đề thi giữa kì 1 lớp 6
Đề thi học kì 1 lớp 6
Đề thi giữa kì 2 lớp 6
Đề thi học kì 2 lớp 6
Thi học sinh giỏi lớp 6
Toán lớp 6
Toán 6 Kết nối tri thức
Giải Toán 6 Chân Trời Sáng Tạo
Toán lớp 6 sách Cánh Diều